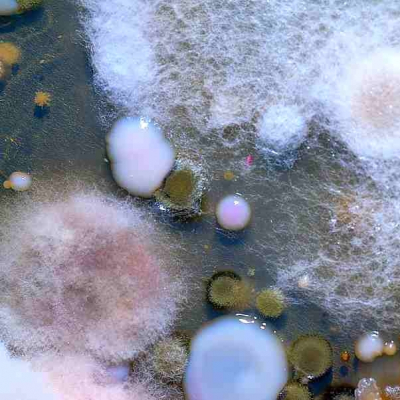
Muffe
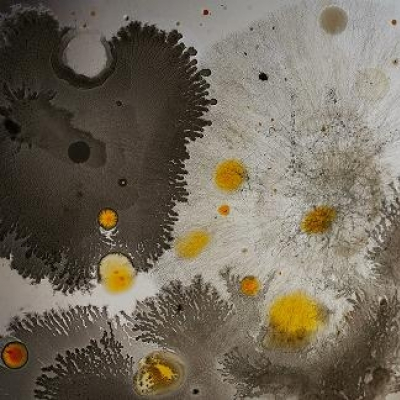
Bacillacea
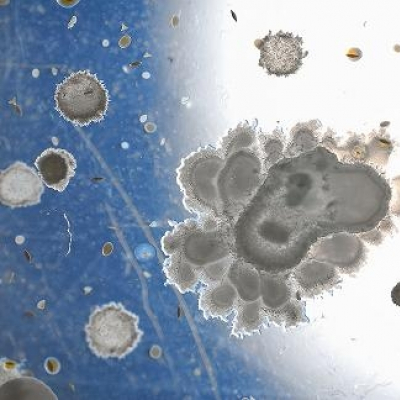
Bacillacea e muffe
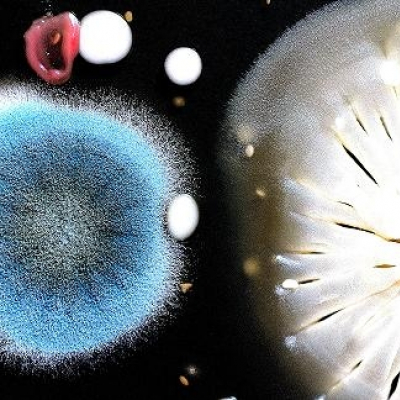
Bacillacea e muffa
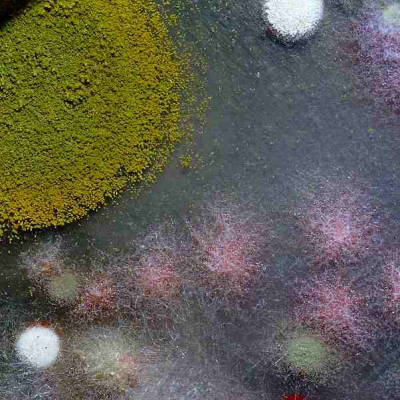
Bacillacea

Il progetto “L’arte invisibile” ha l’intento di valorizzare le opere d’arte create da alcuni batteri cresciuti in piastra Petri. Seguendo il loro istinto naturale si moltiplicano, spaziando con varie forme e tipologie di
colonie. Sono definiti come i primi veri artisti della Terra.
Il progetto che ho realizzato, associa cibo e arte, e si è concretizzato in una serie di fotografie artistiche, dimostrando l’esistenza di un’arte naturale e silenziosa creata da batteri presenti negli alimenti, visibile solo con specifiche tecniche di laboratorio.